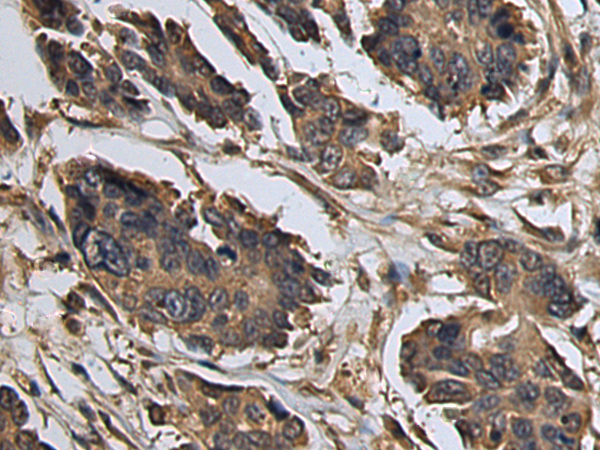

|
Background: |
The protein encoded by this gene is a member of the TNF receptor associated factor (TRAF) protein family. TRAF proteins are associated with, and mediate signal transduction from, members of the TNF receptor superfamily. This protein mediates signaling from members of the TNF receptor superfamily as well as the Toll/IL-1 family. Signals from receptors such as CD40, TNFSF11/RANCE and IL-1 have been shown to be mediated by this protein. This protein also interacts with various protein kinases including IRAK1/IRAK, SRC and PKCzeta, which provides a link between distinct signaling pathways. This protein functions as a signal transducer in the NF-kappaB pathway that activates IkappaB kinase (IKK) in response to proinflammatory cytokines. The interaction of this protein with UBE2N/UBC13, and UBE2V1/UEV1A, which are ubiquitin conjugating enzymes catalyzing the formation of polyubiquitin chains, has been found to be required for IKK activation by this protein. This protein also interacts with the transforming growth factor (TGF) beta receptor complex and is required for Smad-independent activation of the JNK and p38 kinases. This protein has an amino terminal RING domain which is followed by four zinc-finger motifs, a central coiled-coil region and a highly conserved carboxyl terminal domain, known as the TRAF-C domain. Two alternatively spliced transcript variants, encoding an identical protein, have been reported. |
|
Applications: |
ELISA, WB, IHC |
|
Name of antibody: |
TRAF6 |
|
Immunogen: |
Fusion protein of human TRAF6 |
|
Full name: |
TNF receptor associated factor 6 |
|
Synonyms: |
RNF85; MGC:3310 |
|
SwissProt: |
Q9Y4K3 |
|
ELISA Recommended dilution: |
5000-10000 |
|
IHC positive control: |
Human colorectal cancer and Human esophagus cancer |
|
IHC Recommend dilution: |
150-300 |
|
WB Predicted band size: |
59 kDa |
|
WB Positive control: |
Human bladder transitional cell carcinoma grade 2-3 tissue lysate |
|
WB Recommended dilution: |
500-2000 |

購物車
購物車 幫助
幫助
 021-54845833/15800441009
021-54845833/15800441009
